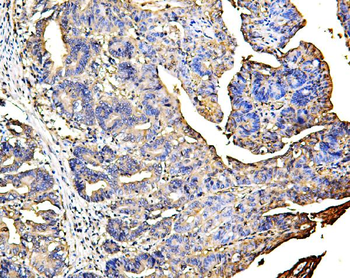
Galectin 3/LGALS3 Antibody (monoclonal, 12B12)
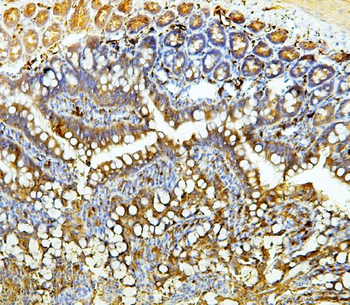
Galectin 3/LGALS3 Antibody (monoclonal, 12B12)

You have no items in your shopping cart.
Human IgE
Description
Images & Validation
−Key Properties
−Storage & Handling
−| Storage | Store at -20°C for one year. Avoid repeated freeze/thaw cycles. |
|---|---|
| Form/Appearance | Liquid |
| Buffer/Preservatives | 0.1M Tris, 0.2M NaCl at pH 7.5. |
| Disclaimer | For research use only |
Alternative Names
−Similar Products
−Coronin 1a/TACO/CORO1A Antibody [orb745941]
ELISA, FC, IHC, WB
Human, Mouse, Rat
Rabbit
Polyclonal
Unconjugated
100 μgGalectin 3/LGALS3 Antibody (monoclonal, 12B12) [orb527053]
FC, ICC, IF, IHC, WB
Human, Mouse, Rat
Mouse
Monoclonal
Unconjugated
100 μgEIF2B1 Antibody [orb669081]
FC, ICC, IF, IHC, WB
Human, Mouse, Rat
Rabbit
Polyclonal
Unconjugated
100 μgHuman Receptor II for the Fc Region of Immunoglobulin E (FceRII) ELISA Kit [orb774970]
Human
0.32-20 ng/mL
0.117 ng/mL
96 T, 48 T

Quality Guarantee
Explore bioreagents carefree to elevate your research. All our products are rigorously tested for performance. If a product does not perform as described on its datasheet, our scientific support team will provide expert troubleshooting, a prompt replacement, or a refund. For full details, please see our Terms & Conditions and Buying Guide. Contact us at support@biorbyt.com.

The purity of the protein is greater than 90% as determined by reducing SDS-PAGE.
Quick Database Links
Documents Download
Request a Document
Protocol Information
Human IgE (orb1608981)
Participating in our Biorbyt product reviews program enables you to support fellow scientists by sharing your firsthand experience with our products.
Login to Submit a Review